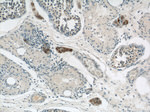
CYP11A1 Antibody in Immunohistochemistry (Paraffin) (IHC (P))

Search
Proteintech
CYP11A1 Polyclonal Antibody
{{$productOrderCtrl.translations['antibody.pdp.commerceCard.promotion.promotions']}}
{{$productOrderCtrl.translations['antibody.pdp.commerceCard.promotion.viewpromo']}}
{{$productOrderCtrl.translations['antibody.pdp.commerceCard.promotion.promocode']}}: {{promo.promoCode}} {{promo.promoTitle}} {{promo.promoDescription}}. {{$productOrderCtrl.translations['antibody.pdp.commerceCard.promotion.learnmore']}}
产品信息
13363-1-AP
种属反应
已发表种属
宿主/亚型
分类
类型
抗原
偶联物
形式
浓度
规格
纯化类型
保存液
内含物
保存条件
运输条件
产品详细信息
Immunogen sequence: MLAKGLPPR SVLVKGCQTF LSAPREGLGR LRVPTGEGAG ISTRSPRPFN EIPSPGDNGW LNLYHFWRET GTHKVHLHHV QNFQKYGPIY REKLGNVESV YVIDPEDVAL LFKSEGPNPE RFLIPPWVAY HQYYQRPIGV LLKKSAAWKK DRVALNQEVM APEATKNFLP LLDAVSRDFV SVLHRRIKKA GSGNYSGDIS DDLFRFAFES ITNVIFGERQ GMLEEVVNPE AQRFIDAIYQ MFHTSVPMLN LPPDLFRLFR TKTWKDHVAA WDVIFSKADI YTQNFYWELR QKGSVHHDYR G (1-300 aa encoded by BC032329)
靶标信息
CYP11A1, also known as cytochrome P450C11A1, cytochrome P450scc and cytochrome P450, subfamily XIA, is an enzyme that catalyzes the first step of steroid biosynthesis under the modulation of cAMP signal. CYP11A1 in steroidogenic cells converts cholesterol to pregnenolone, which is determined by hormonal control of cholesterol availability. Expression of the CYP11A1 gene is controlled by the transcription factor SF-1, and the upstream SF-1 binding site in the CYP11A1 gene is required for hormonal stimulation. c-Jun and SF-1 may act synergistically to activate CYP11A1 gene expression. Both Forskolin and 8-Br-cAMPS elevate CYP11A1 mRNA levels in the interstitial cell monolayer, which has a fully functional adenylate cyclase.
仅用于科研。不用于诊断过程。未经明确授权不得转售。
生物信息学
蛋白别名: cholesterol 20-22 desmolase; Cholesterol desmolase; cholesterol monooxygenase (side-chain cleaving); cholesterol side chain cleavage; cholesterol side-chain cleavage cytochrome P450; cholesterol side-chain cleavage enzyme P450scc (EC 1.14.15.67); Cholesterol side-chain cleavage enzyme, mitochondrial; CYPXIA1; cytochrome P450 11a cholesterol side chain cleavage; Cytochrome P450 11A1; cytochrome P450 family 11 subfamily A polypeptide 1; cytochrome P450 side-chain cleavage enzyme; cytochrome P450 subfamily 11A; Cytochrome P450(scc); cytochrome P450, 11a, cholesterol side-chain cleavage; cytochrome P450, subfamily XIA (cholesterol side chain cleavage); P450(scc); steroid 20-22-lyase; unnamed protein product
基因别名: cscc; CYP11A; Cyp11a-1; CYP11A1; CYPXIA1; D9Ertd411e; P450SCC; Scc
UniProt ID: (Human) P05108, (Rat) P14137, (Mouse) Q9QZ82
Entrez Gene ID: (Human) 1583, (Rat) 29680, (Mouse) 13070